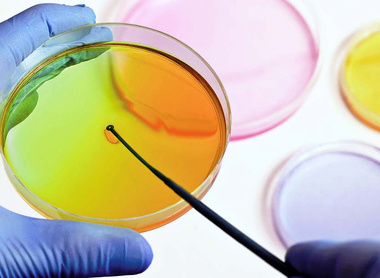
colourful petri dish

About the College
Our vision
Developing and supporting excellence in pathology for healthcare across the world.
The College is a charity with over 13,000 members worldwide. The majority of members are doctors and scientists working in hospitals and universities in the UK.
The College oversees the training of pathologists and scientists working in 17 different specialties, which include cellular pathology, haematology, clinical biochemistry and medical microbiology.
Although some pathologists work in laboratories, many work directly with patients in hospitals and the community. Together, they are involved in the majority of all diagnoses and play an important role in disease prevention, treatment, and monitoring. If you have ever had a blood test, cervical smear or tissue biopsy, a pathologist will have been involved in your care.
President
I am delighted and honoured to be elected as President of the Royal College of Pathologists. Pathology is more important than ever, and as President, I will work to ensure that the work of the College continues to be vital and relevant to members and most importantly to patients.
As President, I will strive to ensure I represent all members across all 17 specialties throughout all stages throughout their career. I will make the case for the vital importance of pathology services in healthcare at every available opportunity.

Dr Bernie Croal became our 21st President on 16 November 2023. Bernie previously served the College as Scotland Regional Council Chair and Vice President from 2011 to 2014. He recently completed his term as President of the Association for Clinical Biochemistry and Laboratory Medicine.
See our past presidents on our Past Presidents page.
Governance
The College is governed by a Trustee Board. Members of the Board, as trustees, have the ultimate legal responsibility for the College. The Trustee Board comprises the President, 3 Vice Presidents, Registrar, Assistant Registrar, Treasurer, the chairs of the regional councils for each of Northern Ireland, Wales and Scotland, two co-opted trustees and 3 lay trustees. The Board is chaired by one of the lay trustees.
Membership
The College offers a comprehensive variety of benefits to support your professional life and to maintain the correct standards of the specialty. Belonging to the College strengthens its ability to act on behalf of all pathologists.
Work opportunities
Thank you for your interest in working for the Royal College of Pathologists. Here you'll see any current staff vacancies available at the College.
If you're a member and interested in supporting the College's work, please head over to our volunteer opportunities page.
College strategy
The Royal College of Pathologists’ Strategy for 2024–2029 sets out our aims for promoting and advancing excellence in pathology.
The College sets the standards for pathology education, training and research, to improve patient care and safety. Ensuring that the curricula, assessments and examinations provided meet the future requirements of the profession and are accessible to everyone interested in pursuing a career in pathology are vital in improving standards globally.
College calendar and College lectures
See what's happening at The Royal College of Pathologists over the coming months, including Committee and panel meetings, key governance dates and annual celebrations.
The College has eight named lectures per annum. View these lectures on our College Lectures page.























